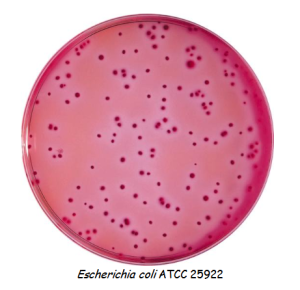

Intended Use
Violet Red Bile Agar (DM286) is used for the enumeration of coliforms in food and dairy product conforms to American Public Health Association (APHA).
Product Summary and Explanation
The coliform group of bacteria includes aerobic and facultative anaerobic, Gram-negative, non-spore forming bacilli. Coliforms ferment lactose and form acid and gas at 35°C within 48 hours. Members of Enterobacteriaceae comprise the majority of the group, but other lactose fermenting organisms may also be included.
Procedures to detect, enumerate, and presumptively identify coliforms are used in testing foods and dairy products.(1-3) Examination of foods, ingredients and raw materials, for the presence of marker groups such as coliforms is the one of the common tests. Violet Red Bile Agar, a modification of MacConkeys original formulation(6) is used for the enumeration of coli-aerogenes bacterial group. It relies on the use of the selective inhibitory components crystal violet and bile salts and the indicator system lactose, and neutral red. Thus, the growth of many unwanted organisms is suppressed, while tentative identification of sought bacteria can be made. Coliform colonies lower the pH of the medium, subsequently causing their colonies to look red to purple and to precipitate the bile salts. Non-fermenters or late lactose-fermenters produce pale colonies with greenish zones.(4) VRBA is recommended by APHA.(5,8) Selectivity of VRBA can be increased by incubation under anaerobic conditions and/ or at elevated temperature, i.e. equal to or above 42°C. (7-10)
Principles of the Procedure
Enzymatic digest of gelatin is the source of carbon, nitrogen, vitamins, and minerals in Violet Red Bile Agar. Yeast Extract supplies B-complex vitamins that stimulate bacterial growth. Bile Salts Mixture and Crystal Violet inhibit most Gram-positive bacteria. Lactose is a carbohydrate source. Sodium chloride maintains the osmotic equilibrium. Neutral Red is a pH indicator. Agar is the solidifying agent.
Formula / Liter
| Ingredients | : Gms / Litre |
| Yeast Extract | : 3.00 |
| Peptic digest of animal tissue | : 7.00 |
| Bile Salts Mixture | : 1.50 |
| Lactose | : 10.00 |
| Sodium Chloride | : 5.00 |
| Neutral Red | : 0.03 |
| Crystal Violet | : 0.002 |
| Agar | : 15.00 |
| Final pH: 7.4 ± 0.2 at 25°C | |
| Formula may be adjusted and/or supplemented as required to meet performance specifications | |
Precautions
1. For Laboratory Use only.
2. IRRITANT. Irritating to eyes, respiratory system, and skin.
Directions
1. Suspend 41.53 grams of the medium in one liter of purified water.
2. Heat with frequent agitation and boil for two minutes. DO NOT AUTOCLAVE.
3. Cool the medium to 45-46°C and dispense 15-20mL into 100mm petri dishes containing inoculum.
4. After solidification of the inoculated medium, evenly add a cover layer of 4 mL of the cooled (45-46°C) agar medium.
Quality Control Specifications
| Dehydrated Appearance | : Light Yellow to pink colored, homogeneous, free flowing powder |
| Solution | : 4.15% Solution in Distilled or deionized water is soluble on boiling, red-purple colored, and very slightly to slightly opalescent. |
| Prepared Medium | : Reddish purple colored slightly opalescent gel. |
| Reaction of 4.15% Solution | : pH 7.4 + 0.2 at 25°C |
| Gel Strength | : Firm, compared to 1.5% Agar Gel. |
Expected Cultural Response: Cultural response on Violet Red Bile Agar at 35-37°C after 18-24 hours incubation.
| Sr. No. |
Organisms | Results to be achieved | |||
| Inoculum (CFU) |
Growth | Recovery | Colour of colony | ||
| 1. | Enterobacter aerogenes ATCC 13048 |
50-100 | luxuriant | >=50% | pink to pinkish red |
| 2. | Escherichia coli ATCC 25922 |
50-100 | luxuriant | >=50% | pinkish red with bile precipitate |
| 3. | Salmonella Enteritidis ATCC 13076 |
50-100 | luxuriant | >=50% | Colourless to orangish yellow |
| 4. | Staphylococcus aureus ATCC 25923 |
50-100 | inhibited | 0% | —- |
The organisms listed are the minimum that should be used for quality control testing.
Test Procedure
Presumptive test for coliforms using solid medium:
1. Transfer a 1 mL aliquot of test sample to a petri dish.
2. Add 10 mL of Violet Red Bile Agar (at 48°C) and swirl to mix.
3. Allow medium to solidify before incubating at 35°C for 18-24 hours; use 32°C for dairy products.
4. Examine for purple-red colonies, 0.5 mm in diameter (or larger), surrounded by a zone of precipitate bile acids.
5. Continue with confirmatory testing of typical organisms colonies.(1-3)
Results
Lactose fermenters are purple-red, with or without a zone of precipitate around the colonies. Lactose non-fermenters are colorless to transparent colonies. Gram-positive cocci are colorless, pinpoint colonies.
Storage
Store the sealed bottle containing the dehydrated medium at 10-30°C. Once opened and recapped, place container in a low humidity environment at the same storage temperature. Protect from moisture and light.
Expiration
Refer to the expiration date stamped on the container. The dehydrated medium should be discarded if not free flowing, or if the appearance has changed from the original color. Expiry applies to medium in its intact container when stored as directed.
Limitations of the Procedure
1. Due to varying nutritional requirements, some strains may be encountered that grow poorly or fail to grow on this medium.
2. VRBA may not be completely inhibitory to Gram-positive organisms, and will grow Gram-negative bacilli other than members of Enterobacteriaceae. Perform a Gram stain and biochemical tests to identify isolates.(7)
3. Boiling the medium for longer than 2 minutes can decrease the ability to support growth.






Reviews
There are no reviews yet.